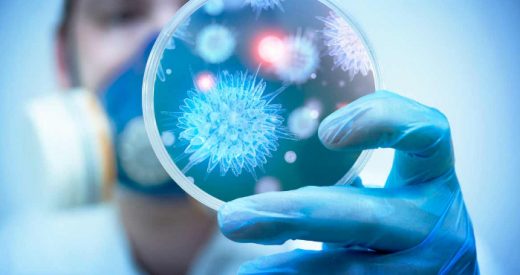
ЯК УНИКНУТИ ІНФЕКЦІЙНИХ ХВОРОБ У МІСЦЯХ ПЕРЕБУВАННЯ ПЕРЕСЕЛЕНЦІВ І БІЖЕНЦІВ?

Особам з інвалідністю проходити повторний огляд під час війни не потрібно
Міністерство охорони здоров’я України нагадує, що на період дії воєнного стану суттєво спрощено процедуру встановлення та продовження інвалідності. Відтепер для отримання соціальних виплат особам з інвалідністю проходити повторний огляд для підтвердження інвалідності не потрібно, оскільки, згідно з постановою КМУ № 390, термін дії інвалідності та Індивідуальна програма реабілітації (ІПР) подовжено на період дії воєнного стану. Строк проходження повторного огляду, який припав на період дії воєнного стану на території України, переноситься на строк не пізніше шести місяців після його припинення/скасування. Діти та дорослі з інвалідністю мають можливість отримувати, відповідно до індивідуальної програми реабілітації, без проходження повторного огляду лікарсько-консультативної комісії (ЛКК) чи медико-соціальної експертної комісії МСЕК: соціальні виплати реабілітаційні послуги та допоміжні вироби (милиці, ходунки, крісла колісні); засоби інконтиненції, наприклад, памперси, катетери тощо освітні послуги; відповідні пільги. Крім того, протягом дії воєнного…
Програма медичних гарантій у 2022 році
Програма медичних гарантій-2022 сфокусована на потребах та безпеці пацієнта. Передусім зміцнюється фінансова захищеність українців завдяки збільшеному бюджету. Також посилюються вимоги до надавачів медичної допомоги, що покращує якість медичних послуг. Програма медичних гарантій-2022 охоплюватиме всі основні види медичної допомоги: первинну, спеціалізовану та високоспеціалізовану допомогу, екстрену, паліативну допомога та медичну реабілітацію. А також медичну допомогу дітям до 16 років та допомогу при вагітності та пологах. Залишаються пріоритетні напрями. А саме: лікування інсульту та інфаркту, медична допомога при пологах, медична допомога новонародженим у складних неонатальних випадках та 6 досліджень для раннього виявлення онкології. Бюджет Програми медичних гарантій 2022 складає понад 157 млрд грн. Це майже на 34 млрд грн більше, ніж у минулому році. Це дозволило підвищити тарифи практично за усіма напрямами надання медичної допомоги. В межах бюджету Програми медичних гарантій-2022 передбачено понад…
В Україні вводять бустерну дозу вакцини проти COVID-19 для всіх вакцинованих
В Україні дозволили бустерну дозу вакцини проти COVID-19 для всіх вакцинованих осіб віком від 18 років. Оптимальний термін ревакцинації – від 6 до 9 місяців після завершення первинного курсу вакцинації незалежно від того, якою вакциною щепилася людина. Введення бустерної дози вакцини проти COVID-19 вже продемонструвало свою безпечність. Вона посилює імунну відповідь та ефективність проти різних актуальних варіантів коронавірусу SARS-CoV-2. На сьогодні дані свідчать, що ефективність вакцин у запобіганні симптоматичному перебігу COVID-19, зумовленому варіантом “Омікрон”, значно нижча у порівнянні з варіантом “Дельта” і швидко знижується з плином часу, особливо серед людей старшого віку. Введення бустерної дози наближає ефективність вакцин до 90% у попередженні госпіталізації внаслідок захворювання на COVID-19. Основною метою вакцинації проти COVID-19 залишається попередження тяжкого перебігу хвороби, особливо серед груп ризику, та збереження життів, а також захист системи охорони здоров’я…
Вітаємо з новорічнимм святами!
☃️Міцного здоров'я Вам в Новому році, лише добрих подій, яскравих моментів в житті, щастя, здійснення всіх надій і поставлених цілей❄️https://www.facebook.com/109012427136780/videos/4983464318372150 З найщирішими побажання КНП "Яготинська ЦМЛ"🧡
Дайджест змін в охороні здоров’я вересень 2021 року
[su_custom_gallery source="media: 921,922,923,924,925,926" link="lightbox" width="730" height="1040" title="never"]
Здорова Україна (дайджест для пацієнтів, вересень 2021)
[su_custom_gallery source="media: 917,918,919,920" link="lightbox" width="730" height="1040" title="never"]
ЗАПРОШУЄМО НА ВАКЦИНАЦІЮ ВІД COVID-19
Шановні мешканці Яготинщини! На сьогоднішній день більше 3000 осіб нашої громади вже щепилися від COVID-19. Не зволікайте, записуйтеся на вакцинацію з понеділка по п'ятницю з 08:00 до 18:00 за телефоном: 04575-5-47-97. Поборемо вірус разом! За матеріалами КНП "Яготинський центр первинної медико-санітарної допомоги"
Україна відкриває вакцинацію проти COVID-19 для всіх охочих
Україна відкриває останній - 5-й етап вакцинації населення проти COVID-19, на якому щеплюватимуть усіх охочих віком від 18 років. При цьому пріоритет надаватиметься вразливим групам населення, зокрема людям віком від 60 років та людям із супутніми захворюваннями. “Ми отримуємо все більше вакцини проти COVID-19 та створюємо все більше пунктів, центрів, мобільних бригад з імунізації. Це дає змогу відкрити вакцинацію для всіх охочих та захистити якомога більше людей від коронавірусної хвороби, зокрема від нового штаму “Дельта”, який вже дістався до України. Водночас у пунктах та центрах вакцинації першочергово щеплюватимуть літніх людей, людей з хронічними хворобами та інші вразливі групи населення”, - зазначив міністр охорони здоров’я України Віктор Ляшко. Серед пріоритетних груп залишаються також медики, освітяни, соціальні працівники та військові, які контактують з великою кількістю людей. Нагадаємо, що вакцинація проти коронавірусної хвороби в…